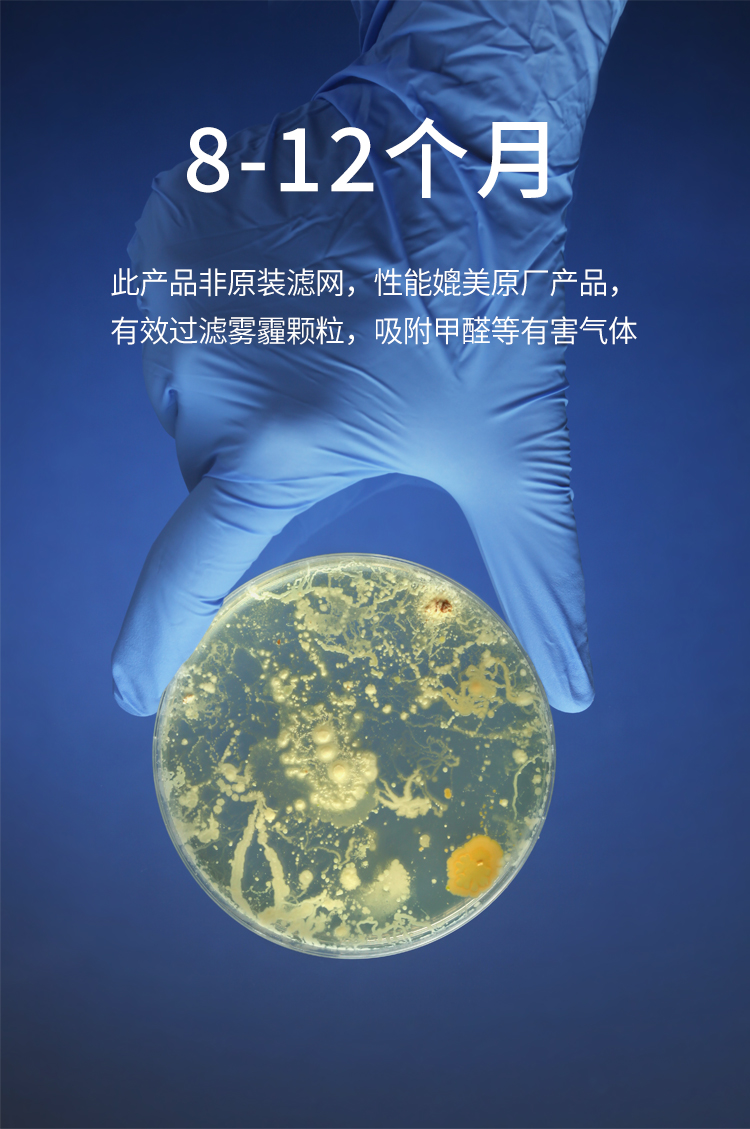

今日の為替レート
お振込銀行
クレジットカード支払い
ログイン | LOGIN
商品カテゴリー
- ブランドファッション
- ファッション/雑貨
- ビューティー
- 食品
- 出産/育児
- 生活雑貨
- パソコン
- レジャー
교체 공기청정기 필터 호환용 데스크 보강제 미세먼지필터 PH04
|
|||||||||||||||||
| 商品購入についてのご案内 | |||
|
|||

교체 공기청정기 필터 호환용 데스크 보강제 미세먼지필터 PH04
상품 이미지




옵션 이미지
색상 분류 : 가습 사전 여과망  | 색상 분류 : 70시리즈필터세트 5종  | 색상 분류 : 50시리즈필터세트 5종  |
색상 분류 : 가습필터  | 색상 분류 : 은이온통  | 색상 분류 : 1차 거름망 6장  |
색상 분류 : EX55시리즈필터세트 5종  | 색상 분류 : EX75시리즈필터세트 5종  | 색상 분류 : EX100시리즈필터세트 4종  |
상세 이미지

세부 사항
| 항목 | 설명 |
|---|---|
| 브랜드 | 역방 |
| 화물번호 | KC-E70 |











